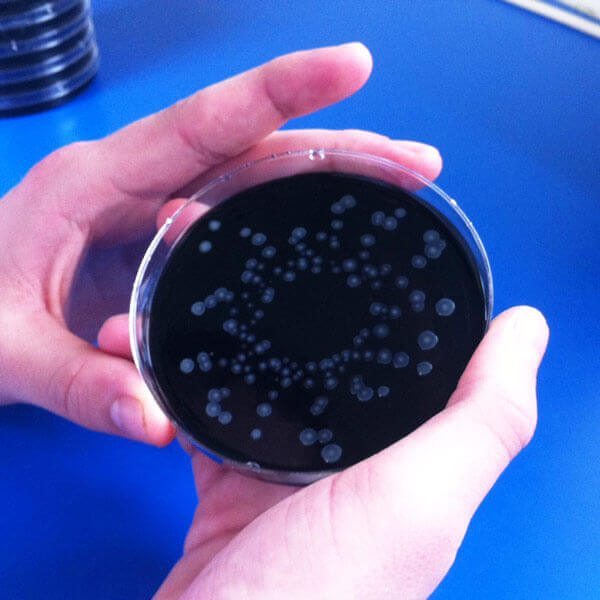

Description
Legionella Testing Analysis Sample Pack
Guidance for when to test can be found in HSG274 Part 2 page 40. Or in your Legionella Risk Assessment if you are a business. If you don’t have a Legionella Risk Assessment for your site you may be breaking the law. Speak to us today about your requirement for a Legionella Risk Assessment.
Ready to order Legionella Sample Kit with Lab Analysis
- UKAS accredited analysis as required by HSE
- Pre-paid return packaging – Order additional if sending samples separately.
- Expert interpretation and advice available
- Immediate reporting of any positive results
- Confidential service
You must not mix more than one sample per bottle, please ensure one sample bottle is used per sample outlet.
Legionella analysis has never been easier – simply click and pay and we will send you a sampling pack and instructions.
You collect the sample and post it back to us in the pre-paid package provided.
How long does it take?
We will start your legionella analysis immediately and send you the testing results as soon as they are available. – With the standard Legionella culture test It takes at least 10 days to confirm a negative result, positive results will be reported as soon as observed. For this reason no (early) news is good news. If you require a test with results much sooner our new pPCR rapid Legionella test can provide unaccredited results in less than 24h click here
Unlike other labs which simply give you results, Feedwater, specialise in solving water related problems so we can explain what the results mean and can provide a full range of services to help you resolve your problem.
What systems should be sampled?
- Cooling Towers and Evaporative Condensers (At least quarterly)
- Healthcare premises (Recommended quarterly)
- Care homes (Recommended quarterly)
- Domestics where temperatures are inadequate to control Legionella (As Required until problem is resolved)
- Buildings where biocides are used instead of temperature (Recommend quarterly until control is established)
- Where there is suspicion of a case of Legionella infection
- Spa Pool operators (At least quarterly)
- Industrial process waters (As required by risk assessment – Talk to us about Legionella Risk Assessments)
- Anybody who needs reassurance that their water system is free of Legionella
We have written an article with the HSG274 guidance to explain when to test water for legionella, this should cover most queries.
Remedial Action following results
[table id=25 /]
[table id=27 /]
About the Analysis
Notes: Legionella testing analysis takes at minimum 10 days to complete, however, if analysis is showing positive for legionella earlier than this you will be notified immediately. For this reason no (early) news is good news.
Please ensure that you post your samples the same day that you collect them and, because our lab is shut at the weekend, plan your sampling so they arrive with us between Monday and Friday i.e. its best to sample between Monday and Thursday but be aware of any bank holidays.
Other Sample Packs
- Microbial Potability Inc TVC
- TVC only
- Pseudomonas
- Enterococci
- Yeasts & Moulds
- Sulphate Reducing Bacteria
- Legionella Testing Kit

Lynsey Handley (verified owner) –
Excellent service – very quick and super efficient.
Venthan Thangeswaran –
Easy prompt service.
Susan Tanzer –
I found Feedwater on Google when looking for Legionnaires Disease water testing. The website gave clear info on their services and fees plus a straight forward application form. I received the pack within days, followed the instruction on water testing and returned the sample as instructed. Within the stated time I received the results by email.
I will use Feedwater again and would certainly recommend them
Colin Haggarty –
A very simple test for Legionella in a property which I rent out. The kit arrived promptly with clear, specific instructions on how to conduct the test. The sample was then sent to the Feedwater lab in the enclosed, pre-paid package, and the results e-mailed back in the form of a certificate. The certificate is now lodged with our Letting Agent, complying with current legislation. Feedwater also advised to do a Risk Assessment, and e-mailed a simple form, which I have also completed and lodged with the Agents. Excellent service and support from this company.
Andrew Aylmer (verified owner) –
We have used Feedwater for a number of years now, mainly for legionella process water testing by post. This has worked well for us and now that we need a site water system risk assessment we have asked feedwater to complete this for us although in the early stages we are confidant that this work will be carried out to to our satisfaction.
John Fraser (verified owner) –
This is the third year that we have used Feedwater to carry out our water sampling to test for Legionella. The process is quick, efficient from placing our order on line for sample bottles to getting the final test results certificates. Highly recommended.
Ian Lowes (verified owner) –
Quick delivery of sample bottle and results spot on